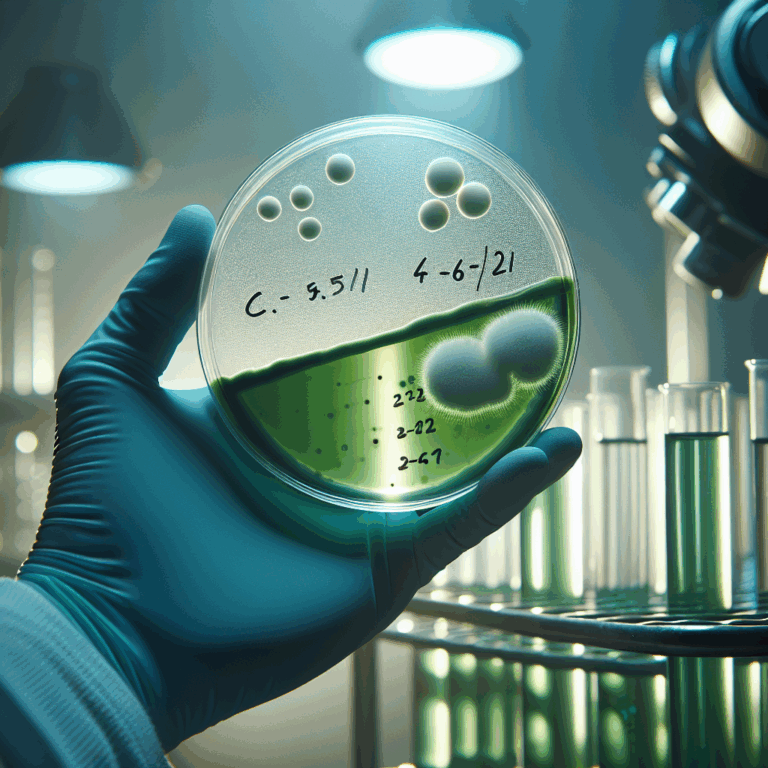

Tappava Sieni Uhkaa Yhdysvalloissa: Aspergillus Fumigatus Lisääntyy
Yhdysvalloissa on havaittu vakava terveysuhka, kun Aspergillus Fumigatus -sieni leviää nopeasti, kertoen brittilehti Daily Mail. Tämä vaarallinen sieni voi mädättää ihmisen kudosta sisältäpäin ja aiheuttaa vakavia keuhkoinfektioita.
Sienen mikroskooppiset itiöt liikkuvat ilmassa, ja ihmiset voivat hengittää niitä huomaamattaan. Sieni on erityisen vaarallinen niille, joiden immuunijärjestelmä on heikentynyt, kuten astmaatikot, syöpäpotilaat ja HIV-tartunnan saaneet.
Vakavissa tapauksissa infektio voi levitä keuhkoista muihin elimiin, kuten aivoihin ja sydämeen, johtuen elimistön puolustuskyvyn heikkoudesta. Lääkärit suosittelevat riskiryhmille varotoimia, kuten kontaktin välttämistä maaperään ja maskin käyttöä pölyisissä ympäristöissä.
Aspergillus Fumigatus viihtyy lämpimissä ja kosteissa olosuhteissa, ja ilmaston lämpeneminen saattaa lisätä sen leviämistä. Sienen aiheuttamia infektioita on raportoitu erityisesti Floridassa, Louisianassa, Texasissa, Georgiassa ja Kaliforniassa, mutta myös suurissa kaupungeissa kuten New Yorkissa ja Los Angelesissa.
WHO on luokitellut Aspergillus Fumigatus -sienen kriittiseksi uhan syntyvän lääkeresistenssin ja korkean kuolleisuuden vuoksi. Lääkeresistenssi voi kasvaa, kun atsolilääkkeitä käytetään niin ihmisten sieni-infektioiden hoidossa kuin maataloudessakin.
Lähde: iltalehti.fi